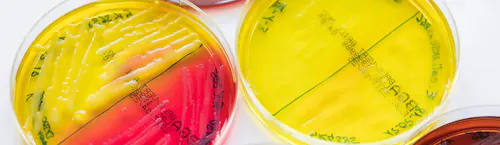
axa partners axa partners

partners|5 mins Lesen
1. Mai 2022
Antibiotika galten lange Zeit als eine hochwirksame Waffe gegen gefährliche Infektionen. Doch es haben sich immer mehr Resistenzen gegen das einstige Wundermittel gebildet. Im Kampf gegen sie forschen smarte Köpfe kreativen Lösungen gegen krank machende Bakterien.
Text:
AXA PARTNERS
Foto:
Heinrich Holtgreve
April 2020
Die Petrischale schimmert im Gegenlicht. Ein besonders widerstandsfähiges Bakterium ist auf einem fruchtbaren Nährboden zwischen zwei Plexiglasscheiben gebannt. So farbenfroh und ungefährlich es auch aussieht, es gehört zu den derzeit größten Bedrohungen für die Gesundheit der Menschheit. Der Keim heißt Klebsiella pneumoniae und hat einen multiresistenten Stamm hervorgebracht, der bei immungeschwächten Patienten in Krankenhäusern tödliche Lungenentzündungen auslösen kann. Derzeit ist dieser mutierte Keim gegen alle zugelassenen Antibiotika resistent.
Marc Gitzinger legt den Erreger zur Seite und zeigt auf eine weitere, dieses Mal gelb gefärbte Petrischale: Hier tummeln sich Escherichia coli. Das sind Bakterien, die sich im Darm besonders wohl fühlen, aber in Körperbereichen, wo sie nicht hingehören, schwere Infekte bis hin zur Blutvergiftung auslösen können. Auch hier gibt es bereits multiresistente Stämme, die gegen mehrere Antibiotika unempfindlich sind. „Ich bin kein Freund von Panikmacherei. Aber die Lage ist nicht zu unterschätzen“, sagt Gitzinger, und der Tonfall des gebürtigen Luxemburgers klingt besorgt. „Gegen die multiresistenten Krankenhauskeime haben wir momentan praktisch nichts in der Hand. Die medizinische Pipeline ist leer.“
Der 36-Jährige ist Geschäftsführer des Baseler Unternehmens BioVersys, das seit 2011 intensiv an neuen Antibiotika forscht – und für Nachschub in dieser Pipeline sorgen will. Am Firmensitz im Technologiepark der Stadt herrscht eine lockere Start-up-Atmosphäre, die Mitarbeiter sind jung, aus einem der Labore tönt laute Rockmusik. Das Problem, mit dem sich Gitzinger und sein Team Tag für Tag beschäftigen, ist aber sehr ernst. Es erfordert einen hochkreativen Lösungsansatz. Gitzingers Vision? Die Programmierung von Bakterien verändern und dabei die Resistenzen einfach ausschalten.
Gitzinger beteiligt sich mit seinem elfköpfigen Team an einem, wie es die Weltgesundheitsorganisation (WHO) bereits 2012 definiert hat, „Wettlauf gegen die Zeit“. Er nennt es einen „Kampf“ gegen Bakterien, „diese winzigen Darwin’schen Evolutionsmaschinen“, wie er sagt. „Sie teilen sich alle 20 Minuten, können sich genetisch verbessern, überleben überall. Deshalb müssen wir den Vorsprung beibehalten. Ansonsten befinden wir uns ganz schnell wieder mitten im 18. Jahrhundert. Wenn wir jetzt nichts tun, riskieren wir den kompletten Fortschritt unserer modernen Medizin. Krebstherapien, Frühgeburten, Operationen, die alternde Gesellschaft, nichts davon funktioniert ohne Antibiotika.“

Resistenzen auf dem Vormarsch
Schon lange warnen Wissenschaftler und Politiker vor einer postantibiotischen Ära: In Europa infizieren sich Schätzungen zufolge circa 2,6 Millionen Patienten jährlich mit multiresistenten Keimen, 91.000 von ihnen sterben an den Folgen, wie Forscher vom Europäischen Zentrum für die Prävention und die Kontrolle von Krankheiten (ECDC) ausgerechnet haben. Allein in Deutschland gibt es ungefähr 15.000 Todesfälle pro Jahr durch die gefährlichen Bakterien, die sich besonders häufig in Krankenhäusern nachweisen lassen. Für gesunde Menschen sind die Bakterien oftmals kein Problem, manche davon tragen sie selbst auf der Haut. Für verletzte oder kranke Patienten mit offenen Wunden aber können die Keime zur lebensbedrohlichen Gefahr werden.
In anderen Regionen der Welt sind die Todeszahlen sogar um ein Vielfaches höher als in Europa: In Indien sterben jährlich allein 60.000 Säuglinge an multiresistenten Bakterien, weil jedes Antibiotikum versagt, fand die britische Fachzeitschrift „The Lancet“ heraus. 70 Prozent aller Indienreisenden, die nach ihrem Urlaub nach Deutschland zurückkehren, tragen resistente Keime im Blut. Benötigen diese später ein bestimmtes Antibiotikum gegen eine Infektion, wirkt das Mittel unter Umständen nicht mehr. Währenddessen verbreiten sich die resistenten Keime in der neuen Heimat. Antibiotika-Resistenzen kennen keine Ländergrenzen.
Kleine Firmen forschen am großen Resistenz-Problem
Wie essenziell die Beteiligung von eher kleinen Playern am globalen Pharmamarkt ist, wird erst beim Blick auf die Konzernriesen klar. Unternehmen wie Aventis (heute Sanofi), Roche oder Eli Lilly zogen sich bereits in den 90er-Jahren aus der Antibiotika-Entwicklung zurück. Die Forschung an den Medikamenten zahlte sich schlichtweg nicht mehr aus. Zudem wurde fast die gesamte globale Antibiotika-Produktion nach der Jahrtausendwende nach China und Indien verlagert. Die Gründe dafür waren vielfältig: Die Gesundheitssysteme der Industrieländer verlangten nach immer günstigeren Medikamenten, zugleich stiegen die Zulassungsanforderungen, viele Patente liefen aus, und billige Generika überschwemmten den Markt. Einige der südostasiatischen Länder hielten sich zudem nicht an aktuelle Patentregeln und produzierten illegal Arzneistoffe. Noch heute werden vor allem in Asien Unmengen von billigen Antibiotika einfach auf der Straße verkauft – was die Resistenzsituation erheblich verschärft.
Für den Mikrobiologen Peter Heisig ist es daher umso ärgerlicher, dass es gerade in der akademischen Forschung an Investitionslust mangelt. Der Universitätsprofessor aus Hamburg forscht schon seit mehr als drei Jahrzehnten zu Antibiotika-Resistenzen und hat diesem Thema damit bereits sein halbes Leben gewidmet. Und er hat nicht vor, in absehbarer Zeit damit aufzuhören.
Hinter einer schweren Metalltür mit gelben, rechteckigen Warnhinweisen im Institut für Biochemie befindet sich der Arbeitsplatz von Heisig und seiner Forschergruppe.

Das Bakterium unter der Lupe
Der 59-Jährige streift sich schnell einen Laborkittel über, bevor er den riesigen Eisschrank öffnet, in dem sich mehr als 5.000 verschiedene Bakterienkulturen befinden. Die Erreger, mit denen die Universität Hamburg arbeitet, sind auf minus 80 Grad Celsius gekühlt, damit sie möglichst lange haltbar bleiben. Heisig nimmt die Keime unter die Lupe und will verstehen, wieso und wie sich Resistenzen bilden. „Erst dann kann man anfangen, diese Vorgänge zu unterbinden“, sagt er. Für echte Erfolge ist Heisig, genau wie seine Universitätskollegen, auf die Kooperation mit der Industrie angewiesen. Ohne Geld lassen sich keine Innovationen vorantreiben. Die Universitäten können die Mittel für die teure Antibiotika-Forschung jedoch nicht allein aufbringen.
Der Kostenfaktor in der Antibiotika-Entwicklung
„Für die Pharmaindustrie ist der Anreiz für die Entwicklung neuer Antibiotika heute immer noch sehr gering“, erläutert Heisig. „Die Kosten für einen neuen Wirkstoff liegen geschätzt bei circa einer Milliarde Dollar. Diese Summe kann man nicht einfach durch den Verkauf eines Medikaments, das auch noch besonders sparsam eingesetzt werden soll, wieder einfahren. Bei einer Infektion, die mit Antibiotika behandelt wird, ist der Patient im besten Fall nach zehn Tagen wieder gesund. Diese Rechnung kann gar nicht aufgehen.“
Der Gesamtumsatz für die aktuell sechs erfolgreichsten Antibiotika summiert sich auf gerade einmal 500 Millionen Dollar in den ersten zwei Jahren nach der Markteinführung. Zum Vergleich: Januvia, ein Wirkstoff gegen Diabetes, fuhr bereits im zweiten Jahr einen Umsatz von mehr als einer Milliarde Dollar ein. Das ist der Mechanismus des Kapitalismus: Chronische Erkrankungen lohnen sich, bakterielle Infektionen dagegen nicht.
Umso wichtiger ist es, dass man für Universitäten die Möglichkeit schafft, jene Grundlagenforschungen zu übernehmen, aus denen sich die Großkonzerne bereits vor Jahrzehnten zurückgezogen haben. Dafür müsste die Schere zwischen akademischer und kommerzieller Forschung endlich geschlossen werden: „Wenn man für sein Projekt keinen geeigneten Partner aus der Pharmaindustrie findet, kann es sein, dass wir zwar gute neue Wirkstoffe entwickeln, es diese aber niemals aus unseren Laboren zu den Patienten schaffen“, sagt Heisig.
Kleine Firmen treiben kreative Forschungsprojekte voran
Auch der Schweizer Forscher Marc Gitzinger ist mit seiner Firma BioVersys auf Investoren angewiesen, die in seine millionenschweren Forschungen investieren und an den Erfolg des Unternehmens glauben. „Das Gute an einer kleinen Firma wie unserer ist ja gerade, dass wir auch risikoreichere, kreative Projekte vorantreiben können“, erzählt er. „Weil wir von Risikokapitalgebern finanziert werden, können wir uns zunächst auf die Entwicklung der Technologie konzentrieren. Der wirtschaftliche Aspekt spielt auch eine Rolle, kommt aber erst später dazu.“ Das heißt im Klartext: Umsatz wird von BioVersys zwar noch nicht erwartet, Ergebnisse aber schon. Und die kann Gitzinger liefern. Derzeit arbeitet er mit seinem Team an drei vielversprechenden Projekten, die bakteriellen Infektionen allesamt den Garaus machen wollen.
Das erste Projekt widmet sich einem „schlauen“ Molekül, das bei der Behandlung von Tuberkulose eingesetzt werden soll. „Tuberkulose ist per se immer noch die bakterielle Krankheit, die mit weltweit 1,5 Millionen Todesfällen am meisten Menschen umbringt“, erklärt Gitzinger. Das Gravierende an den neuen Tuberkulose-Fällen: Mittlerweile sind eine halbe Million Betroffene gegen die verabreichten Antibiotika resistent. Gitzingers Molekül soll diese Resistenz aber nicht nur ausschalten, sondern das Medikament sogar noch stärker machen: „Das Mittel ist ein sogenannter Potenziator. Bislang haben wir keinen Tuberkulose-Stamm gefunden, bei dem das Mittel die Resistenz nicht ausstellen kann“, erklärt Gitzinger stolz. Und um stolz zu sein, hat er jeden Grund: Das Medikament ist nur zwölf Monate von seiner klinischen Entwicklung und nur fünf Jahre von einer Markteinführung entfernt – rein theoretisch. In der Praxis hat Gitzinger einen großen Pharmapartner, der sich um Produktion und globalen Vertrieb kümmert, noch nicht finden können.

Innovative Ansätze gegen Resistenzen
Das smarte Tuberkulose-Molekül ist aber längst nicht die einzige Idee, die Gitzinger in petto hat, um den Erregern die Stirn zu bieten. Mit einem zweiten Projekt will er den Schutzwall der Bakterien, den sogenannten Biofilm, unterbinden. Dieser legt sich oftmals wie eine schützende Hülle über eine Bakterienkolonie und sorgt dafür, dass kein Antibiotikum die Entzündung mehr erreichen kann. Ein Problem, das zum Beispiel oft nach Hüftoperationen auftaucht.
„Das dritte Projekt ist besonders innovativ“, sagt Gitzinger. „Hier untersuchen wir, was eigentlich passiert, bevor die Entzündung im Körper ihren Höhepunkt erreicht und ausbricht.“ Ziel ist es, diesen Entzündungsprozess genau zu verstehen, um dann präventiv eingreifen zu können. „Wenn wir einen Wirkstoff verabreichen könnten, der unser Immunsystem unterstützt und dafür sorgt, dass die Infektion gar nicht erst ausbricht, dann wäre das die Lösung für viele Probleme.“ Das Präventivprojekt ist auch deshalb so wichtig, weil es sich gegen die gefährlichsten aller Keime richtet: gegen die sogenannten multiresistenten gramnegativen Bakterien.
„Die Bakterien haben Evolutionsbedingt nachgerüstet. Jetzt müssen wir kreativ werden und neue Wege Gehen.“
Alle wichtigen und wirklich innovativen Ansätze in der Antibiotika-Forschung haben gemeinsam, dass sie nicht auf so viele Bakterien wie möglich zielen, sondern ganz spezifisch gegen eine bestimmte Population vorgehen. Nur so wird man sich auch gegen die multiresistenten Krankenhauskeime wappnen können. Die Zeit von Breitbandantibiotika ist abgelaufen, da sind sich die Forscher Heisig und Gitzinger einig.
Anreize für die Antibiotika-Entwicklung
Damit Unternehmer und Wissenschaftler gleichermaßen auch weiterhin ihren Dienst an der Menschheit fortsetzen und in ihren Laboren innovative Wirkstoffe entwickeln können, muss man für die Industrie neue Anreize schaffen. Eine Möglichkeit, über die derzeit viel diskutiert wird, sind die sogenannten „Market Entry Awards“. Das bedeutet: Unternehmen, die gerade ein neues Antibiotikum herausgebracht haben, bekommen als Prämie eine gewisse Summe zur Verfügung gestellt. Dabei wäre es wichtig, dass eine unabhängige Institution, wie zum Beispiel die WHO, nicht nur die Prämie, sondern auch das neue Antibiotikum kontrolliert.
Vorher müssen sich der öffentliche Sektor sowie Politik und Wirtschaft zunächst einig werden, sonst führen auch die besten Innovationen weiterhin nur in die Sackgasse. „Wir brauchen noch sehr viele gute Wirkstoffe“, sagt Peter Heisig. „Die Resistenzproblematik wird immer bestehen bleiben. Es wird kein Antibiotikum geben, das für immer wirkt.“
So denkt auch Gitzinger: „Die Bakterien haben evolutionsbedingt nachgerüstet. Jetzt müssen wir kreativ werden und neue Wege gehen.“